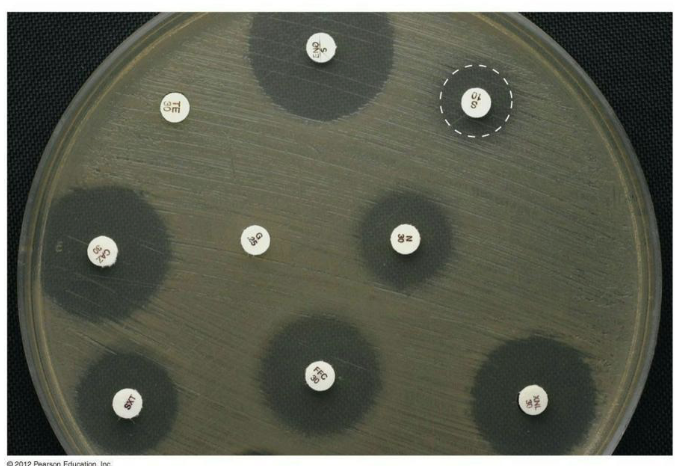
<p><strong><em>Standardizations</em></strong>:</p><ul><li><p>Size of the agar plate</p></li><li><p>Depth of the media</p></li><li><p>Media composition (no PABA)</p></li><li><p>The number of organisms (0.06 OD at 600 nm)</p></li><li><p>Size of the disks</p></li><li><p>Concentration of antibiotics in the disks</p></li><li><p>Incubation temperature</p></li></ul><p></p>

Chapter 13: Control of Infectious Diseases
1/47
There's no tags or description
Looks like no tags are added yet.
Name | Mastery | Learn | Test | Matching | Spaced | Call with Kai |
|---|
No analytics yet
Send a link to your students to track their progress
48 Terms
What are vaccines, and how are they used to control infectious diseases?
History of vaccination
Smallpox (variola virus) is a historic illness plaguing humankind.
It is viral in nature and easily transmitted via aerosols.
The mortality rate is up to 50 to 90%.
Edward Jenner coined the term vaccination in 1798 with his work protecting people from smallpox.
Jenner observed that milkmaids had smallpox less frequently than the rest of the population but they would get a lesser disease (cowpox).
He purposely infected a boy with cowpox, then later with smallpox—and the boy didn’t develop the disease.
He less risky than variolation practiced previously – purposeful inoculation of live smallpox virus into the skin or a vein or by inhalation through the nose

What is the history of vaccination?
Fast-forward 150 years, and technology had improved enough for a concerted global vaccination effort.
This effort was successful, eliminating smallpox in the wild.
Government research labs maintain the last known quantities of the wild virus for research purposes.

What is vaccine design?
Vaccines confer protection by initiating immune memory.
Specialized T and B cells that are produced post- stimulation
T and B cells possess immune receptors that bind to antigen
Antibody is the secreted form of the B-cell receptors
The ideal vaccine generates a high level of immune memory without serious side effects.
Different types of vaccines include
[1] Attenuated
[2] Inactivated
[3] Subunit
[4] Nucleic Acid (DNA or mRNA)
![<ul><li><p>Vaccines confer protection by <strong><em>initiating immune memory.</em></strong></p><ul><li><p>Specialized T and B cells that are produced post- stimulation</p></li><li><p>T and B cells possess immune receptors that bind to antigen</p></li><li><p>Antibody is the secreted form of the B-cell receptors</p></li></ul></li><li><p>The ideal vaccine generates a high level of immune memory without serious side effects.</p></li><li><p>Different types of vaccines include</p><ul><li><p>[1] <strong>Attenuated</strong></p></li><li><p>[2] <strong>Inactivated</strong></p></li><li><p>[3] <strong>Subunit</strong></p></li><li><p>[4] <strong>Nucleic Acid (DNA or mRNA)</strong></p></li></ul></li></ul><p></p>](https://assets.knowt.com/user-attachments/a9c27f9a-a11e-4c73-8cd8-52bc1b100251.png)
What are attenuated vaccines in vaccine design?
Composed of living (but weakened) pathogen.
Tend to produce high immunity because the microbe replicates in the body.
This exposes the immune system to a higher level of foreign antigen over a greater period of time.
An added benefit is the individual might shed vaccine microbe to other individuals, indirectly vaccinating them.
There is a possibility that the weakened pathogen could revert to a more pathogenic state, however.
One of the polio vaccines.
What are inactivated vaccines in vaccine design?
Consist of whole virus/cells that have been inactivated by heat or chemicals.
The microbe can’t revert, can’t replicate, and can’t spread.
Drawbacks include lower/shorter stimulation of immune responses, a need for multiple injections, and greater risk of negative side effects.
An example of an older vaccine (no longer in use) was killed whole-cell pertussis (Bordetella pertussis) vaccine.
Crude prep of microbial components.
Induced convulsions in 0.1% of infants (with a smaller percentage suffering brain damage).
Newer vaccine is a safer – acellular subunit prep.
What are subunit vaccines in vaccine design?
Consist of 1+ isolated protective antigens (no whole cells or viruses)
Defined composition is safer.
May require several injections to produce strong immunity.
The current DTaP (or Tdap) vaccine (diphtheria, tetanus, and pertussis).
Conjugate vaccines are a modified form of this method.
They link a polysaccharide antigen to an immunogenic protein.
The idea is that the polysaccharide is a poor antigen on its own.
When you link it to a strong stimulating protein, you can get better responses overall.
Example: The Hib vaccine, protecting against H. influenzae bacteria (meningitis).
What is a DNA (vector) vaccine in vaccine design?
Consist of a cloned gene(s) in a DNA vector.
Delivered to cells by injection, engineered virus, or electroporation
If the gene is picked up and expressed, it stimulates a protective immune response.
Similar to recombinant subunit vaccines
Benefit is longer exposure (stronger response).
Vaccines don’t contain live microbes, avoiding the dangers associated with attenuated vaccines.
Example: Astra Zeneca SARS-CoV2 vaccine

What are mRNA vaccines in vaccine design?
Consist of an antigen-encoding mRNA complexed with a carrier (lipid nanoparticles).
Delivered in vivo into the cytoplasm of host cells for protein translation and post- translational modification
mRNA vaccines are non-infectious and are synthesized by in vitro transcription, free of microbial molecules.
Safer, efficient and lack issues of antivector immunity.
Rapid and inexpensive production and repeated vaccination.
Example: Moderna and Pfizer SARS-CoV2 vaccines

What is vaccine efficiency?
No vaccine is 100% effective, but efficacy has been studied extensively.
Childhood vaccine effectiveness rates are usually 85–90%.
Estimating infected individuals in a population becomes a numbers game.
Opponents of vaccination use these numbers to argue that vaccines do not work—which is a misrepresentation.
Imagine if no one was vaccinated, instead...
What is herd immunity?
In reality, you can never immunize 100% of a population ... but you don’t have to.
If you can effectively reduce the number of susceptible individuals, an illness can’t progress in a population effectively.

What is the herd immunity threshold?
Herd immunity threshold = % of population that needs to have immunity to prevent spread of a disease
This value can depend on:
The susceptibility of the population
How communicable the disease agent is
Population density
Vaccine efficiency
If herd immunity is high enough, global eradication of a disease is possible.
R0 is the average number of new infections caused by an infected individual in a population of susceptible individuals.

How was Polio a near success?
Poliovirus is transmitted via the fecal–oral route.
In most cases, a mild gastrointestinal illness results.
In a smaller percentage of cases, the virus “takes a wrong turn” and enters the central nervous system.
This can result in varied degrees of paralysis.

What are the changing patterns of infection for Polio?
In endemic areas with poor sanitation and water quality, incidence of paralytic polio is low.
Most individuals are infected very early in life, and chances of the “wrong turn” event are lower.
In endemic areas with improved sanitation and water quality, exposure to poliovirus occurs later in life.
Chances for paralytic polio increase with age.
This is genuinely a case where improvements in sanitation and water quality may have exacerbated the issue of paralytic polio.
We can’t go back to poor sanitation—so vaccinate!

What are inactivated vs attenuated polio vaccines?
Inactivated polio vaccine (IPV, “Salk” vaccine) began being used in 1955.
Attenuated oral polio vaccine (OPV, “Sabin” vaccine) began being used in the 1960s.

How was foot-and-mouth disease the making of an epidemic?
FMDV is a close relative of the poliovirus.
It is very easily spread by numerous methods.
The R0 value is between 36 and 73.
It causes high mortality in young animals and cripples adult animals by producing painful lesions.
To head off the disease, animals are often slaughtered and burned en masse.

Why are animal populations sometimes kept unvaccinated?
Animal populations are sometimes kept unvaccinated—Why?
Vaccination prevents adequate testing (all tests show positive).
Risky move but keeping a population unvaccinated and attempting to enact policy to keep infected animals out can be done.
This resulted in disaster in the UK in 2001, with an estimated $8.5 billion loss and 6.5 to 10 million animals slaughtered.
Was the cost of remaining unvaccinated worth it?
What kinds of drugs are used to treat infections, and how do they work?
Antimicrobial drugs are different from antiseptics and disinfectants.
They are often administered internally.
They exhibit selective toxicity (more toxic to an infectious microbe than to the host/host cells).
They may be of natural origin, semisynthetic or synthetic.
They may be highly effective at eliminating one class of microbes (e.g., bacteria) while ineffective at eliminating others.
Their history of use extends across the past century.
Why are antibiotics important?
Antibiotics are the most important, historically.
Alexander Fleming in 1928
Observations of bread mold Penicillium inhibiting S. aureus cultures
Led to a surge in research on naturally occurring antibiotic compounds
Analysis of molecular structure
Led to classification
Further research on devising synthetic equivalents

What can antibiotics often interfere with?
Antibiotics often interfere with
Cell wall (peptidoglycan) synthesis
Membrane integrity
DNA synthesis
Transcription
Folic acid synthesis
Ribosome function
Structure often determines what can be affected.
Different features can also impact cost and delivery methods. Ex. Acid resistance

What is the spectrum of action?
Spectrum of Action – Number of different pathogens a drug acts against
Narrow-spectrum effective against few organisms
Broad-spectrum effective against many organisms
May allow for secondary or superinfections to develop
Killing of normal flora reduces microbial antagonism

What are the types of antibacterial drugs?
Bacteriocidal = Directly kill the microbes treated
Bacteriostatic = Prevent replication of bacteria but do not kill them
Selected classes of antibacterial drugs:
Inhibitors of peptidoglycan synthesis
Inhibitors of ribosome function
Inhibitors of nucleic acid synthesis

What are inhibitors of peptidoglycan (PTG) synthesis?
These drugs can inhibit crosslinking of PTG or interfere with a step in its actual synthesis.
Penicillins bind to penicillin-binding proteins (PBPs) in microbes irreversibly.
Gram-negative cell PBPs are in the periplasm, where the drugs typically can’t reach.
Chemical modification of the drugs can make them more likely to reach the periplasm, increasing the spectrum to Gram-negative cells.
Gram-positive cell PBPs are in the outer cell wall, making them more susceptible to such drugs.
Some microbes lacking PTG cell wall structures are naturally resistant to these drugs.


What are inhibitors of ribosome function?
Antibacterial: Inhibitors of ribosome function
Bacterial ribosomes are an excellent target for selective toxicity.
They are different in structure from eukaryotic ribosomes.
Many of these drugs exploit those differences.
Macrolides
Chloramphenicol
Aminoglycosides and Tetracyclines

What are inhibitors of nucleic acid synthesis?
Quinolones inhibit DNA gyrase/Topoisomerase IV.
Causes DNA to tear itself apart during unwinding for synthesis
Sulfonamides are a structural analog (and competitive inhibitor) for para-aminobenzoic acid (PABA), a necessary precursor for synthesis of nitrogenous bases.
Trimethoprim prevents synthesis of nitrogenous bases by inhibiting an enzyme in the folic acid pathway.

What are antifungal drugs?
Much more problematic (eukaryotes!)
Very few available drugs, and the few must focus on
Disruption of cell ergosterol (instead of cholesterol in human cell membranes)
Ex. Azole class drugs
Inhibition of chitin cell wall structures
Selective inhibition of the formation of microtubules needed for mitosis (difficult!)

What are antiprotozoal drugs?
Differences in protozoan structures and varied life cycle forms complicates things.
Basic drug methods include (but are not limited to):
Inhibition of heme detoxification inside malaria parasites as they feed on hemoglobin (chloroquine)
Free radical formation in presence of ferrous iron effective against malaria parasites in erythrocytic stage (artemisinin)
Destruction of DNA by incorporation of drugs into new DNA that causes breakage of the strands (metronidazole)
What are antiviral drugs?
Tricky because viruses often use host cell processes
If you inhibit a host cell process, toxicity will be high.
Common mechanisms involve:
[1] Preventing viral attachment to, or release from, host cells
[2] Inhibition of DNA synthesis – only for DNA viruses (viral DNA polymerase) or retroviruses (reverse transcriptase)
Often through nucleoside/nucleotide analogues
Azidothymidine (AZT) – HIV, dideoxythymidine analog
Acyclovir – herpes, guanosine analog
[3] Inhibition of RNA synthesis
Ribavirin – Hepatitis C, guanosine analog
Can pair with C or with U – produce mutations in subsequent rounds of replication because they cannot be correctly interpreted by polymerase

![<ul><li><p>Tricky because viruses often use host cell processes</p><ul><li><p>If you inhibit a host cell process, toxicity will be high.</p></li></ul></li><li><p>Common mechanisms involve:</p><ul><li><p>[1] <strong>Preventing viral attachment to, or release from, host cells</strong></p></li><li><p>[2] <strong>Inhibition of DNA synthesis</strong> – only for DNA viruses (viral DNA polymerase) or retroviruses (reverse transcriptase)</p></li><li><p>Often through <strong>nucleoside/nucleotide analogues</strong></p><ul><li><p><strong>Azidothymidine (AZT)</strong> – HIV, dideoxythymidine analog</p></li><li><p><strong>Acyclovir</strong> – herpes, guanosine analog</p></li></ul></li><li><p>[3] <strong>Inhibition of RNA synthesis</strong></p><ul><li><p><strong>Ribavirin</strong> – Hepatitis C, guanosine analog</p><ul><li><p>Can pair with C or with U – produce mutations in subsequent rounds of replication because they cannot be correctly interpreted by polymerase</p></li></ul></li></ul></li></ul></li></ul><img src="https://assets.knowt.com/user-attachments/693b7467-5cfe-4d7e-a76b-8f61ab40f6a5.png" data-width="75%" data-align="center"><p></p>](https://assets.knowt.com/user-attachments/336ee4ba-1465-4d17-823b-9d9839c4bc3d.png)
How can the effectiveness of antibacterial drugs be determined?
Effectiveness of antibacterial drug can be determined by:
Kirby-Bauer Diffusion Test
Minimal Inhibitory Concentration (MIC)
Usually measured in μg/mL
Minimal Bactericidal Concentration (MBC)
Lowest concentration that kills ≥99.9% of bacterial cells
Time-Kill Assays
Bacterial viability tests
In vivo Models
Animal models or clinical trials
What are zones of inhibition in a diffusion susceptibility (Kirby-Bauer) test, specifically the standardizations?
Standardizations:
Size of the agar plate
Depth of the media
Media composition (no PABA)
The number of organisms (0.06 OD at 600 nm)
Size of the disks
Concentration of antibiotics in the disks
Incubation temperature
What is the MIC test?
Minimum inhibitory concentration (MIC) test in test tubes or multi-well plates

What is the MBC test?
A minimum bactericidal concentration (MBC) test
1.6 μg/mL – bacteriostatic concentration
3.1 μg/mL – bactericidal concentration

What are the safety considerations and side effects?
Toxicity
Cause of many adverse reactions poorly understood
Drugs may be toxic to kidneys, liver, or nerves
Consideration needed when prescribing drugs during pregnancy
Allergies
Allergic reactions are rare but may be life threatening
Anaphylactic shock
Disruption of normal microbiota
May result in secondary infections
Overgrowth of normal flora causes superinfections
Of greatest concern for hospitalized patients

What is the timeline for antimicrobial drug resistance?

How do microbes become drug-resistant?
Adaptation to selective pressures drives genetic change in microbes.
Drug resistance genetic changes are negative.
The CDC estimates 2 million people contact bacterial infections in hospitals yearly.
Of these, approximately 23,000 die.
About 70% of the bacterial pathogens causing these infections show resistance to at least one antibacterial drug.

What is the evidence for selection for resistance in clinical settings?
Changes in antimicrobial drug use are positively correlated with changes in prevalence of resistance.
Increasing antibiotic treatment lengths increases resistant-microbe colonization rates.
The more antimicrobial drug use in a facility, the more drug resistance that can be found.
Patients with resistant strains receive antibiotics more often (providing selective pressure).
What are the molecular mechanisms of resistance?
Generally, due to four possible mechanisms:
Producing enzymes that modify or destroy the drug
Altering binding targets of drugs
Preventing drug entry into the target cell
Pumping the drug back out of the target cell (efflux pumps)

How is resistance to β-lactams achieved?
Resistance to β-lactams achieved in four ways:
β-lactamase production (drug inactivation)
Often mediated through genes carried on R plasmids
Alteration of penicillin-binding proteins (PBPs) (alteration of drug target site)
Reduction of membrane permeability to the drug (drug inaccessibility)
Efflux (pumping) of the drug from the cell

How does resistance to chloramphenicol occur?
Resistance to chloramphenicol usually occurs in two major ways:
Production of chloramphenicol acetyltransferase (drug inactivation)
Reduction of the membrane permeability to the drug (drug inaccessibility)

What is resistance to sulfonamides?
Resistance to sulfonamides
Mainly occurs through alterations to the enzyme dihydropteroate synthetase.
This enzyme is inhibited by sulfonamides that act as a competitive inhibitor against the usual substrate, PABA.
Modifying the active site to reject the drug (but still accept the normal substrate) helps to confer resistance.

What is natural selection and drug resistance?
Microbes will genetically adapt to drug selective pressures through
Random mutations
Recombination
Horizontal gene transfer mechanisms
Most changes will have no effect on drug resistance.
However, with continued drug therapy (continued selective pressure), rare genetic changes can quickly produce a dominant resistant microbe strain.
What two aspects must be considered in natural selection and drug resistance?
Two aspects must be considered:
[1] Most treatment works synergistically with the immune system.
It doesn’t have to eliminate all microbes.
It just has to give the immune system a fighting chance.
[2] Therapeutic levels must be used that are high enough to help eliminate microbes, but low enough to avoid toxicity.
![<p><strong><u>Two</u></strong> aspects must be considered:</p><p>[1] Most treatment works synergistically with the immune system.</p><ul><li><p>It doesn’t have to eliminate <em>all</em> microbes.</p></li><li><p>It just has to give the immune system a fighting chance.</p></li></ul><p>[2] Therapeutic levels must be used that are high enough to help eliminate microbes, but low enough to avoid toxicity.</p>](https://assets.knowt.com/user-attachments/3e31a289-2ebb-4e76-ac6d-86a17cf6ccf6.png)
What is the origin of drug resistance genes (natural resistance)?
Natural resistance (without drugs)
Intrinsic drug resistance due to natural structure or metabolism
May be due to lack of access to a target/transport molecule (as in Gram-negative PBPs)
May be due to a side-effect of normal function (efflux pumps in fungal cells)
Resistance genes in the environment
When one microbe in a complex microbial ecosystem secretes a natural antibiotic compound, it can provide a selective pressure on other microbes.
This is microbial warfare in a natural setting (without human intervention).
What is the origin of drug resistance genes (resistance to antimicrobial drugs)?
Penicillin-resistant strains of microbes began appearing shortly after penicillin entered widespread use—how do these mechanisms arise?
Mechanisms vary quite widely, but two include
[1] Modification of preexisting genes
Spontaneous mutations (polymerase errors)
Exposure to mutagens inducing mutations
[2] Acquiring new resistance genes by
Transposable elements
Transducing phages
Plasmid transfer (transformation/conjugation)
Recombination events
![<ul><li><p>Penicillin-resistant strains of microbes began appearing shortly after penicillin entered widespread use—how do these mechanisms arise?</p></li></ul><p>Mechanisms vary quite widely, but two include</p><p>[1] Modification of preexisting genes</p><ul><li><p>Spontaneous mutations (polymerase errors)</p></li><li><p>Exposure to mutagens inducing mutations</p></li></ul><p>[2] Acquiring new resistance genes by</p><ul><li><p>Transposable elements</p></li><li><p>Transducing phages</p></li><li><p>Plasmid transfer (transformation/conjugation)</p></li><li><p>Recombination events</p></li></ul><p></p>](https://assets.knowt.com/user-attachments/47c900dc-4276-4bd1-bc4f-a7823463782e.png)
What are the mechanisms of acquiring new genetic material?
A. Conjugation
B. Transduction
C. Transposition
D. Recombination

What is the rapid rise of resistance?
The rapid rise of resistance
Resistance tends to appear only 4 to 5 years after a drug’s introduction. How does it appear so quickly?
Resistance arises quickly through combined action of
Transfer of whole resistance genes by mobile genetic elements
High frequency of random mutations
Recombination events
Short generation times (24 hours or less for many microbes versus 2.5 days for some of the fastest-reproducing multicellular organisms)
Drug makers are fighting these problems with new technology for smarter and faster drug design.
What is antimicrobial resistance in farmed animals?
Antimicrobial resistance in farmed animals
Agriculture is the 1st largest consumer of antimicrobial drugs.
40-80% of all antibiotic use is in farmed animals.
Antibiotic use increases animal size and weight.
Healthier animals = more profit.
A difficult problem to define fully or change by policy as different countries have different standards and policies for agriculture and farm animal feeds.
It is entirely possible that overuse of antibiotics may contribute to antimicrobial resistance in human pathogens, but data is inconclusive to this point.
What do we do about the problem of antimicrobial drug resistance?
Combating drug resistance
Several approaches exist that, if used collectively, may help reduce the problem.
Reduce use.
Use selective drugs.
Use multidrug cocktails.
Use effective infection control.
Develop new vaccines and improve access.
Develop alternatives/develop drugs in a smarter way.
What is Lasso?
A broad-spectrum lasso peptide antibiotic targeting the bacterial ribosome
Lasso peptides (biologically active molecules with a distinct structurally constrained knotted fold
Lariocidin (LAR), a lasso peptide produced by Paenibacillus sp.
Represents the first in class of antibiotics that inhibit bacterial growth by binding to the ribosome resulting in mistranslation and interfering with protein biosynthesis by impairing translocation
Dual mechanism of action – binds to 16S rRNA and A-site tRNA
Mostly insensitive to mutations or enzymatic resistance mechanisms that cause high levels of resistance to other antibiotics that target the ribosome
Lack of cytotoxicity
Demonstrated efficacy in an animal model of A. baumannii infection
